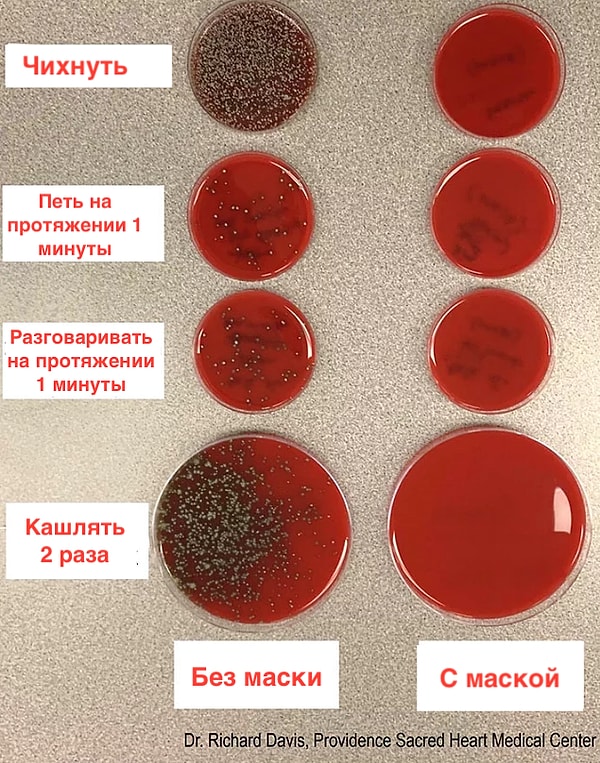
👇
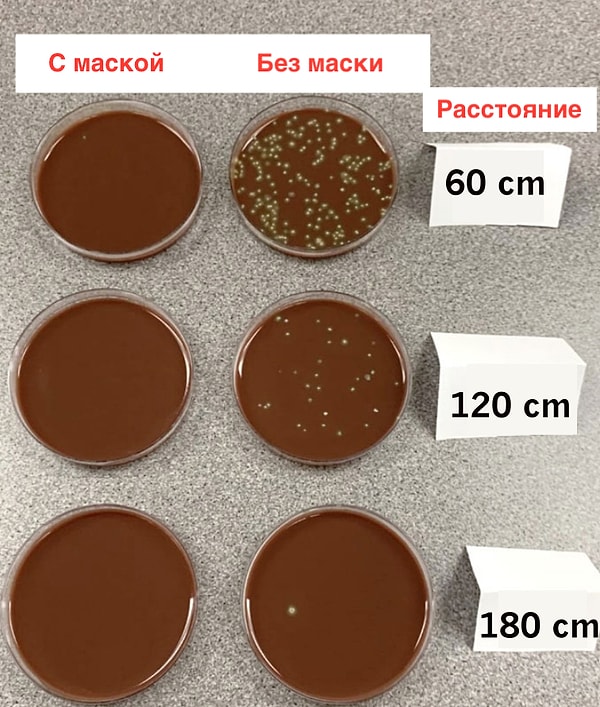
👇

Ученый продемонстрировал защитные свойства маски с помощью эксперимента
Носите маски, соблюдайте дистанцию!
Рич Дэвис показал на своей страничке в Твиттере, насколько важно носить маску.

'Для чего нужна маска? Она блокирует передачу дыхательных капель из вашего рта и горла. В моем эксперименте я попытался показать, что происходит, когда вы чихаете, поете, разговариваете и кашляете в маске и без маски.'
👇
Он также обратил внимание на важность социальной дистанции.

'Итак, как влияет расстояние? Во втором эксперименте, который я сделал, я кашлял на расстоянии 60,120 и 180 см в течение 15 секунд. Я выполнил тот же процесс как с маской, так и без нее. Как вы можете видеть на фотографии ниже, маска помогла заблокировать большую часть.'
👇
"Я понимаю, что этот эксперимент не совпадает с тем, как мы распространяем вирусы и атипичную пневмонию-CoV-2.”

'Но я думаю, что способ распространения бактерий, выходящих из моего рта/горла, в значительной степени похож на способ распространения КОВИД-19, и маска предотвращает это распространение.'
Дэвис считает, что значение маски вышло за пределы ее главного предназначения, и стала политической и социальной лакмусовой бумажкой.

'Также, как мы моем руки после посещения туалета или вытираем нос с помощью салфеток, маски являются еще одной 'нормальной' практикой, которую мы используем для нашей гигиены.#масказащищает'
"В этом смысле я хочу довольно четко выразить, когда маски защищают, а когда нет.”

'Разговоры, кашель, чихание и пение заставляют частицы жидкости выходить из вашего рта.”
'Эти капли могут содержать внутри микробы, такие как бактерии.”
'И маска блокирует подавляющее большинство из них.”
"Можете ли вы протестировать разные маски с одним и тем же экспериментом? Да. Будет ли это по-другому? Ну. Не совсем."

'Маска, которая предотвращает появление вашей слюны и дыхания из вашего рта, предотвратит распространение некоторых бактерий и, возможно, вируса.'
"Вы на 100% правы, что бактерии и вирус полностью отличаются друг от друга.”

“Но если мы будем основываться на распространении дыхательных капель в этом эксперименте, который я сделал, я считаю, что аналогичная ситуация будет связана с вирусом нового типа коронавируса. Кроме того, этот эксперимент очень эффективен для воплощения ситуации.”
Keşfet ile ziyaret ettiğin tüm kategorileri tek akışta gör!


Напишите комментарий